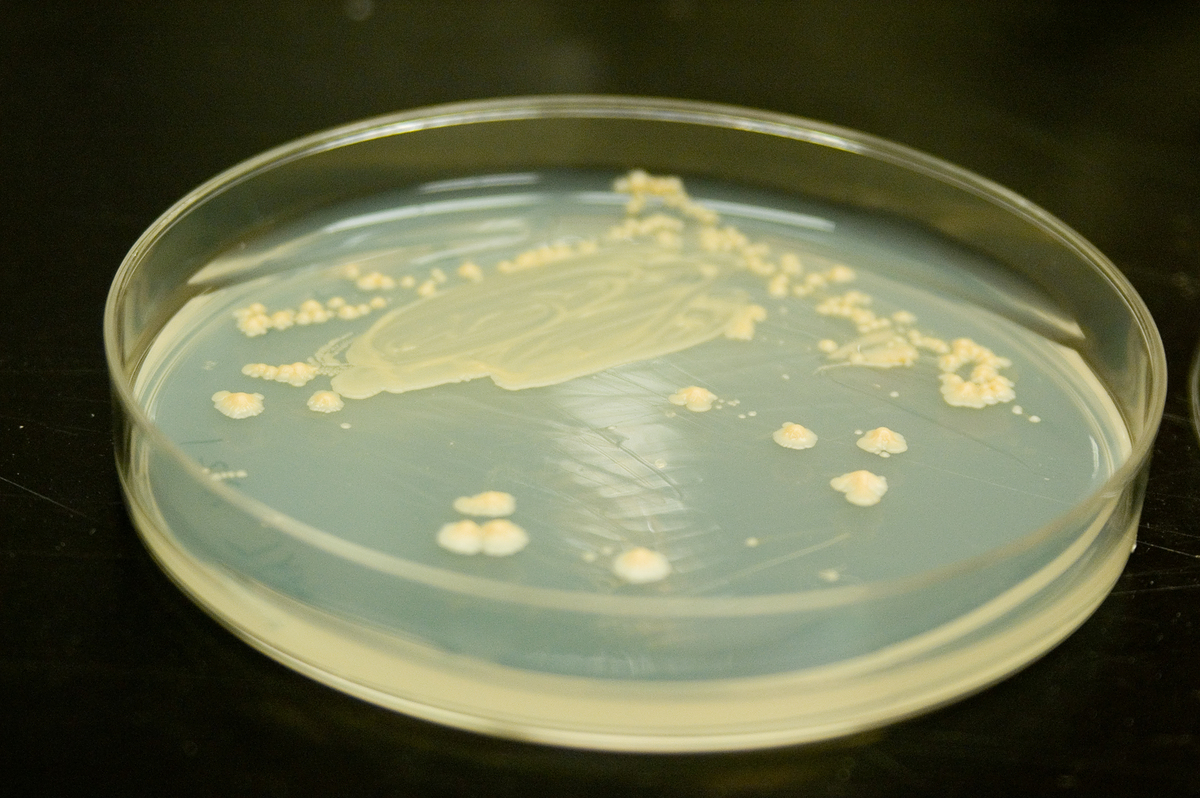
Understanding of sources microbial contamination is paramount

At first sight, the need to control the pre-sterilisation contamination on a product that will be terminally sterilised seems paradoxical. Peter Rose, managing director, High Edge Consulting, and Synergy Health’s Mark Botting explain the whys and wherefores.
It stands to reason that manufacturers of medical devices should control the contamination of products they are manufacturing and this is particularly true for sterile products. Regulations fall under two broad umbrellas: the Quality Management System (QMS) requirements and the Regulatory requirements. It is not always easy to separate these as one is often a function of the other. Contamination control should be approached holistically in any case, but for the purposes of this article they are mentioned separately.
QMS requirements mandate manufacturers to maintain control of the manufacturing environment with regard to contamination. For the USA, this is laid down by 21 CFR 820.70(c) which states: “(c) Environmental control. …the manufacturer shall establish and maintain procedures to adequately control these environmental conditions…” For Europe, Canada and other key world markets the requirements are covered by ISO 13485:2003 paragraph 6.4, which states: “Work Environment: The organisation shall determine, and manage the work environment needed to achieve conformity to product requirements.”
The Medical Devices Directives, applicable in Europe, but also the basis for similar regulation in other key world markets, have specific requirements concerning microbial contamination.
In the main medical devices directive, 93/42/EEC as amended, under Annex I, the Essential Requirements, section 8 covers the requirements for “Infection and microbial contamination”. Sub-paragraph 8.5 states: “Devices intended to be sterilised must be manufactured in appropriately controlled (e.g. environmental) conditions.”
To address the earlier apparent paradox regarding contamination control of terminally sterilised products there are three main considerations.
The first is the regulatory requirements introduced above. Apart from the legal need to comply, manufacturers need to appreciate the inactivation kinetics of sterilisation technologies, which work on a logarithmic reduction basis. While sterility itself is an absolute, the state of sterility is expressed in terms of probability as the “Sterility Assurance Level” (SAL). Because any sterilisation process is finite and entirely dependent upon the microbial loading, or the “bioburden” – without control of the bioburden the SAL cannot be accurately controlled.
Because any sterilisation process is finite and entirely dependent upon the microbial loading, without control of the bioburden the Sterility Assurance Level cannot be accurately controlled
The second consideration is the effect of non-viable contamination on the human body. Not all contamination is viable. Bacterial endotoxins are one of the most significant pyrogens associated with sterile medical devices. Pyrogens are substances that cause a heat rise in the body; increasing levels of pyrogens can cause a fever and ultimately death. Bacterial endotoxins are fragments of the cell wall of Gram negative bacteria: live Gram negative bacteria shed endotoxins, and dead Gram negative bacteria liberate significantly more endotoxins. When a device carries contamination of Gram negative bacteria the very act of sterilising it liberates endotoxins.
Finally, contamination also comprises non-viable contamination. Devices containing significant particulate and/or fibre contamination that come into contact with blood and/or cerebrospinal fluid (CSF) have the potential to cause blockages, thromboses or other adverse reactions.
Environmental controls
Cleanrooms are the default choice for the control of the manufacturing area, but the best a cleanroom can achieve is to “not add” to the contamination of a medical device during its manufacture, assembly and packaging.
Cleanrooms are classified according to particle size using the relevant standard ISO 14644-1:1999. Typical classification is carried out at 0.5μm, and often at 5.0μm too. For medical devices there are no hard and fast rules regarding which classification of cleanroom is required against any product type. Experience shows that medical device cleanrooms are commonly Class 7 for implants and surgically invasive devices or Class 8 for less critical applications.
Risk analysis
“Manufacturers would be well advised to determine their cleanliness requirements as a result of a formal risk analysis exercise since some Notified Bodies are beginning to require the rationale more formally,” recommends Mark Botting, UK commercial director at Synergy Health.
Significant sources of contamination inevitably are from cleanroom personnel, who contribute approximately 80% of all contamination that is found within the cleanroom
Contamination falls into two broad categories: viable and non-viable. Significant sources of contamination inevitably are from cleanroom personnel, who contribute approximately 80% of all contamination that is found within the cleanroom. Examples of the non-viable fall into two categories of fibrous contamination (e.g eyelashes and clothing fibres) and particulate contamination (e.g. scabs, blusher, etc).
Apart from that caused by people, the other sources of contamination are the products, raw materials and any automation used in the production process. It is important to have good control over raw materials that enter the cleanroom environment, not just in terms of good and effective transfer procedures but also with regard to the origin of the raw materials and their supply chain.
Low quality raw materials have the ability to contaminate the cleanroom themselves. Where there is any doubt about the microbial quality of raw materials and/or their supply chain, bioburden testing should be undertaken before their release for use.
Where there is any doubt about the microbial quality of raw materials and/or their supply chain, bioburden testing should be undertaken before their release for use
With regard to maintaining sterility of a medical device, the standard, ISO11137-2: 2006 “Sterilization of health care products – Radiation – Part 2: Establishing the sterilization dose” clearly outlines the need for stable as well as low bioburden. It is therefore important that the variation in bioburden is monitored as spikes can cause dose audit failures and potentially product recalls.
“One of the most common reasons for dose audit failures is due to the variation of raw materials from natural sources or that have been transported from another continent,” states Botting. “The need to specify the microbiological quality plus the transport route and time is therefore key but is often overlooked in purchasing agreements.”
Effects of contamination include potential for infection, physical damage and metabolic/immunological responses. A lack of control over contamination can lead to sterility failures that have the very real prospect of causing infection, which can potentially require medicinal or surgical intervention, or even amputation and potentially death.
Non-viable contamination
Fibre and particulate contamination can cause varying degrees of physical damage, from low level problems such as minor blockage of arterioles to larger scale blockages of critical blood pathways, thromboses and ultimately death. Fibrous contamination has the ability to damage valves within the venous system, which can be very painful and lead to oedema and similar consequences.
The potential for metabolic/immunological responses is virtually limitless as it is caused by whatever contamination may be present on the device. Soap residues from poorly rinsed hands or contamination with paint-stripper residue following a weekend’s DIY are all potential contaminants eliciting a metabolic/immunological response.
Bacterial endotoxin as a function of sterilised contamination has the capacity to kill.
Environmental monitoring in medical device cleanrooms is normally a combination of settle plates and contact plates. Less commonly, active air monitoring is undertaken. Virtually all cleanrooms will monitor for bacterial contamination and better programmes will also include an assessment for yeasts and moulds.
Settle plates monitor the fallout rate onto a surface and are a good monitor of the microbial air quality, while contact plates directly measure the contamination present on a surface and give an effective measurement of efficacy of cleaning processes. Contact plates should contain a neutralising agent against disinfectant residues that would otherwise mask microbial contamination by inhibiting growth of contaminants on the agar growth medium.
Bioburden is a measure of bacterial contamination and represents the pre-sterilisation viable population of micro-organisms on a product. It is the measure of viable contaminants destined to be killed by the sterilisation process.
There are many classes of bacteria and it is impractical, if not impossible, to assess them all for the purposes of bioburden determination unless there are specific circumstances to pinpoint. Bioburden is therefore the counting of non-fastidious mesophilic aerobic bacteria.
Similarly, unless there are compelling reasons to do so fungi (yeasts and moulds) are not assessed, as it is the bacteria that are normally more prevalent and more important. Other micro-organisms such as viruses, protozoa and algae are rarely assessed. It is important to note that bioburden is an assessment of the total count and not just pathogens. Bioburden does not include prions or endotoxin.
Bioburden is the final arbiter as to whether control measures have been effective, but as a final figure it is quite coarse since it measures the combination of materials and activities, including:
- Raw materials
- Sub-assembly operations
- Sub-assembly storage conditions
- Assembly operations
- Packaging
- Cleaning processes
- Operators’ hygiene controls
- Cleanroom operation
- Cleanroom efficiency
- Storage time and conditions
Since 80% of all cleanroom contamination comes from personnel, the majority of control measures surround people and their activities. Most human contamination comes from either respiratory activities or hand contact.
Effective hand washing with a bactericidal soap at the start of a shift is effective in removing gross contamination, both physical dirt and microbes, but for the biocidal activity of the soap to be fully effective operators need to have due regard for the manufacturer’s stated contact time for the biocidal effects to be fully realised.
“Although it may seem obvious, training in hand washing should be more than a tick box exercise and does have an impact on bioburden levels,” stresses Botting. “We recently had a high routine bioburden result for a customer and were involved in investigating this as they were unable to find the reasons behind it.
“After walking around the cleanroom and watching the staff get changed it became obvious that a new starter was not aware of the hand washing requirements. This was therefore solved very easily and although it did not lead to product recall, it could have done so and the commercial impact would have been significant.”
Gloves have their place in cleanrooms, particularly for critical care and highly invasive devices; however, beware of the illusion of no contamination from the gloved hand.
Understanding of sources microbial contamination is paramount
Dangerous talk
“Talking is often overlooked as a risk activity,” adds Botting. “The very act of talking gives out far more contamination than simply passively breathing. Cleanroom operators sitting face to face during final inspection and discussing the day while they examine products will be inadvertently spitting over them while they talk.”
Personnel suffering from any respiratory disorder, dry skin condition or gastrointestinal disorder are not suitable for work in the cleanroom. Likewise, injuries and cuts are a risk and need to be carefully handled.
Larger and perhaps more obvious contamination is contained by the cleanroom facility itself with pre-filters and terminal HEPA filters providing a constant supply of clean air to the cleanroom at an overpressure helping to prevent the ingress of unfiltered air into the manufacturing environment.
Talking is often overlooked as a risk activity. The very act of talking gives out far more contamination than simply passively breathing
Out of specification (OOS) situations should initiate immediate containment, both physical and electronic, of affected product pending results of product impact assessments and investigations. Beware the knee-jerk retest, which achieves very little since one ‘Pass’ result and one ‘Fail’ result is hardly conclusive.
“There must be a documented rationale to justify discounting original test result and believing the retest result. Retests are useful, however, in determining the extent of the issue as part of the investigation process,” adds Botting. “If high bioburden results are seen during a dose audit, but the product still passes, then it is still important to investigate this even though product recall would not be required.
“It is also perfectly reasonable to question the test laboratory, but any doubt over the laboratory process must be evidence-based. If the laboratory skill is deemed to be ‘in doubt’ then this doubt should be applied to all test results including those where tests have successfully passed.”
Investigations for OOS results are not always straightforward and classic quality tools such as the Fish Bone (Ishikawa) diagram can be very effective in tracking down the root cause. Useful information can be obtained from a detailed review.
The regulatory requirements for contamination control are quite general in nature yet the practicalities of effective control can be intricate. The impact of a lack of control can be minor but also has the capacity to be devastating and companies ignore proper control at their peril. Because of the large number of inputs into a cleanroom environment there is a wide range of control measures that should be implemented, all culminating in control that may be assessed through just a few practical monitoring tests.
A review and assessment of control plans with microbiologist support is strongly encouraged.




